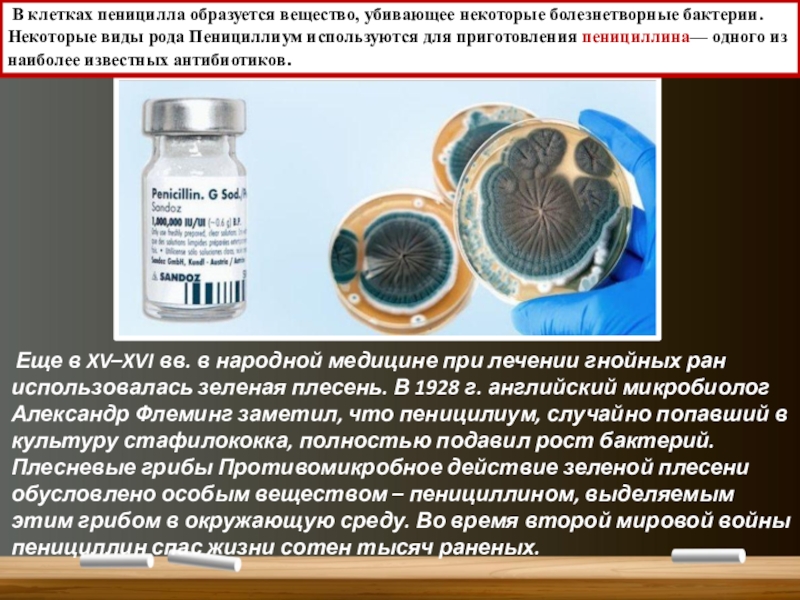

- Главная
- Разное
- Образование
- Спорт
- Естествознание
- Природоведение
- Религиоведение
- Французский язык
- Черчение
- Английский язык
- Астрономия
- Алгебра
- Биология
- География
- Геометрия
- Детские презентации
- Информатика
- История
- Литература
- Математика
- Музыка
- МХК
- Немецкий язык
- ОБЖ
- Обществознание
- Окружающий мир
- Педагогика
- Русский язык
- Технология
- Физика
- Философия
- Химия
- Шаблоны, фоны, картинки для презентаций
- Экология
- Экономика
Презентация, доклад по биологии на темуПлесневые грибы( 5 класс)
Содержание
- 1. Презентация по биологии на темуПлесневые грибы( 5 класс)
- 2. Содержание урокаПеницилл на страже здоровья.Применение дрожжей человеком
- 3. 1. Мёртвыми органическими веществами питаются грибы-
- 4. Плесневые грибы.Плесневые грибы. Плесневые грибы развиваются в
- 5. Мукор- белая плесеньМицелий ветвящийся, многоядерный, состоящий из одной клетки и имеющий вид белой плесени.
- 6. Образует многочисленные вертикальные спорангиеносцы со спорангиями. В
- 7. Мукор и его споры. увеличение х
- 8. При истощении субстрата(объекта на котором развивается гриб)
- 9. Плесневые грибы Род Пенициллиум.Этот гриб встречается в
- 10. клетки с перегородками (конидиеносцы)Грибница пенициллиума состоит из
- 11. Конидии со спорами
- 12. В клетках пеницилла образуется вещество, убивающее
- 13. Плесневые грибы Пенициллин применяют при пневмонии, сепсисе,
- 14. Но зеленые плесени успешно применяются не только
- 15. Дрожжи под микроскопом. Увеличение в 3000 разДрожжи.Дрожжи-
- 16. Размножение дрожжей происходит и бесполым путем с
- 17. Слайд 17
- 18. Ответьте устно на вопросы1. В тесто для
- 19. Сравнительная таблица по плесневым грибам Мукор и Пеницилл
- 20. Слайд 20
Слайд 3 1. Мёртвыми органическими веществами питаются грибы- ….. 2. Шляпочные грибы состоят из
7. Гриб при помощи грибницы получает от дерева:…….
8. Дрожжи размножаются:……….
9. По способу питания грибы похожи на животных, так как они………..
10.Питаются за счёт живых организмов грибы- …..
11.Плодовое тело шляпочного гриба образовано …. и …..
12. Между конями деревьев и грибницей грибов устанавливается полезная связь- …..
ВЕЩЕСТВА,СПОРЫ,ЯДОВИТЫЕ,ШАРИКА, САПРОТРОФЫ, ПЛОДОВОЕ ТЕЛО, ОРГАНИЧЕСКИЕ ВЕЩЕСТВА, ПОЧКОВАНИЕ,ГЕТЕРОТРОФЫ,ПАРАЗИТЫ, ШЛЯПКА,СИМБИОЗ, НОЖКА, ТРУБЧАТЫЕ , ПЛАСТИНЧАТЫЕ
Слайд 4Плесневые грибы.
Плесневые грибы. Плесневые грибы развиваются в почве, на увлажненных продуктах,
Слайд 5Мукор- белая плесень
Мицелий ветвящийся, многоядерный, состоящий из одной клетки и имеющий
Слайд 6Образует многочисленные вертикальные спорангиеносцы со спорангиями.
В спорангиях образуется до 10
Спорангиеносцы
(вертикальные гифы мицелия)
Слайд 7 Мукор и его споры. увеличение х 600
споры
спорангиеносцы
Новые гифы
спорангий
Попадая в подходящие условия, споры прорастают и дают начало новому мицелию мукора.
Слайд 8При истощении субстрата
(объекта на котором развивается гриб) мукор переходит к половому
Специальные клетки- гаметы
Новые гифы - мицелий
Спорангиеносец с спорангием
Слайд 9Плесневые грибы Род Пенициллиум.
Этот гриб встречается в виде плесени (зеленого, сизого,
Гриб Пеницилл.
Слайд 10клетки с перегородками
(конидиеносцы)
Грибница пенициллиума состоит из множества клеток с перегородками,
Споры пенициллиума расположены в кисточках- конидии
Слайд 12 В клетках пеницилла образуется вещество, убивающее некоторые болезнетворные бактерии.
Некоторые виды
Еще в XV–XVI вв. в народной медицине при лечении гнойных ран использовалась зеленая плесень. В 1928 г. английский микробиолог Александр Флеминг заметил, что пеницилиум, случайно попавший в культуру стафилококка, полностью подавил рост бактерий. Плесневые грибы Противомикробное действие зеленой плесени обусловлено особым веществом – пенициллином, выделяемым этим грибом в окружающую среду. Во время второй мировой войны пенициллин спас жизни сотен тысяч раненых.
Слайд 13Плесневые грибы Пенициллин применяют при пневмонии, сепсисе, гнойничковых заболеваниях кожи, ангине,
Слайд 14 Но зеленые плесени успешно применяются не только в медицине. Большое значение
сыр «Стилон»
сыр «Горгонцола»
сыр «Рокфор»
Слайд 15Дрожжи под микроскопом.
Увеличение в 3000 раз
Дрожжи.
Дрожжи- одноклеточные грибы, образующие колонии.
Не имеют мицелия и представляют собой неподвижные клетки овальной формы размером 2—10 мкм с одним ядром.
Слайд 16Размножение дрожжей происходит и бесполым путем с помощью почкования и половым
Слияние гамет
Слайд 18Ответьте устно на вопросы
1. В тесто для выпечки хлеба добавляют пекарские
3. Какие особенности строения и жизнедеятельности грибов объединяют их с растениями и животными?
4. Что такое спорангиеносцы и конидиеносцы? У каких грибов они встречаются?